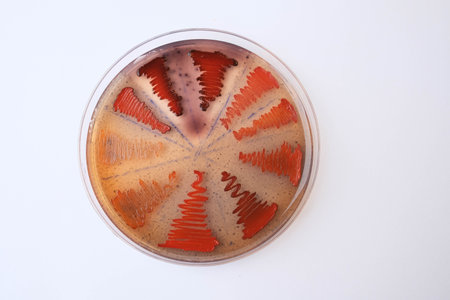
closeup photo of bacterilal colonies grown on agar mediaの写真素材

写真素材 - closeup photo of bacterilal colonies grown on agar media
キーワード
- agar
- analysis
- assay
- bacteria
- biochemistry
- biofilm
- biofilm production
- biology
- biotechnology
- black colony
- chemical
- clinical
- colonies
- congo red agar
- culture
- diagnostics
- dish
- equipment
- experiment
- glassware
- gram
- growth
- inspection
- iraq
- isolated
- lab
- laboratory
- liquid
- media
- medical
- medicine
- microbiology
- microorganism
- morphology
- nature
- petri
- pick up
- pigment
- plate
- red agar
- research
- sample
- science
- scientific
- single colony
- slime
- staphylococcus
- streak plate
- test
- top view
類似作品
Backgrounds of ...
Backgrounds of ...
Backgrounds of ...
Abstract ink te...
Air bubbles ins...
Backgrounds of ...
Mixed of bacter...
Backgrounds of ...
Colony characte...
Red on a blue. ...
Staphylococcus ...
Backgrounds of ...
Backgrounds of ...
Backgrounds of ...
Backgrounds of ...
Backgrounds of ...
Backgrounds of ...
Yeast in petri ...
Abstract ink te...
Backgrounds of ...
Backgrounds of ...
Backgrounds of ...
Colony characte...
Backgrounds of ...
Backgrounds of ...
Staphylococcus ...
Colony characte...
Characteristics...
Backgrounds of ...
Backgrounds of ...
Colonies of mic...
Bacterial colon...
Mold Beautiful,...
Backgrounds of ...
Backgrounds of ...
Backgrounds of ...
Mold Beautiful,...
Bacterial colon...
white and purpl...
Backgrounds of ...
Backgrounds of ...
iron textures
Backgrounds of ...
Melioidosis sic...
Backgrounds of ...
Yeast in petri ...
Backgrounds of ...
Backgrounds of ...
Backgrounds of ...